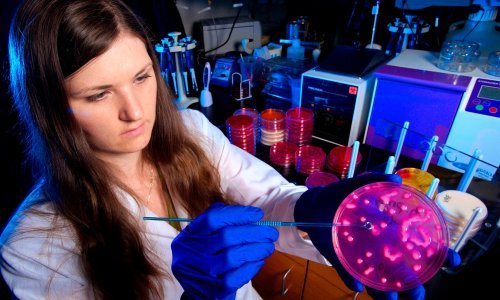

Stručnjaci predlažu nekoliko projekata koji bi mogli olakšati i ubrzati reakciju na iduću pandemijsku prijetnju, među kojima se nalazi stvaranje baze podataka o genomima dosad nepoznatih virusa te globalna mreža prikupljanja krvnih i fekalnih uzoraka
Otkad su krajem prošle godine u Kini zabilježeni prvi slučajevi, koronavirusom SARS-CoV-2 do danas je diljem svijeta zaraženo više od deset milijuna osoba, a od posljedica respiratorne bolesti Covid-19, koju izaziva virus, umrlo je više od pola milijuna ljudi. Nakon oštrog odgovora u ožujku i travnju u znatnom broju država strogim izolacijskim i karantenskim mjerama stvorila se nada da će doći do postepenog stišavanja pandemije, no posljednje brojke, posebno one iz Sjedinjenih Američkih Država i Brazila, pokazuju da je čovječanstvo još uvijek daleko od toga.
Broj novozaraženih tako dnevno redovno prelazi 150 tisuća ljudi, a od bolesti svakog dana premine i po pet tisuća osoba. Čak je i u Hrvatskoj, koja se mogla pohvaliti inicijalnom reakcijom na pandemiju i koja je broj novozaraženih u jednom razdoblju svela na nulu, opet došlo do razbuktavanja epidemije i posljednjih dana kod nas se otkrivaju deseci novih slučajeva. Tako smo se opet našli na svojevrsnom početku i mada neki spominju da bi se ponovni rast mogao tumačiti kao drugi val zaraze, s druge se strane čuju upozorenja da drugi val tek predstoji i da bi mogao stići ujesen. Pandemija tzv. španjolske gripe otprije stotinu godina je kroz tri glavna vala trajala dvije godine, a procjenjuje se da je sveukupno tada zaražena četvrtina čovječanstva, odnosno pola milijarde ljudi, i da je preminulo nekoliko desetaka milijuna oboljelih.
S tim u vidu postavlja se pitanje jesmo li se za aktualnu pandemiju mogli bolje pripremiti i, još važnije, možemo li se bolje pripremiti za neku eventualnu buduću. U britanskom tjedniku The Economist ovih dana podsjetili su da je još početkom 2018. stručni panel pod pokroviteljstvom Svjetske zdravstvene organizacije (WHO, World Health Organization) napravio listu bolesti za koje ne postoje protumjere, a koje predstavljaju značajan rizik za javno zdravlje. Među bolestima poput ebole ili zika groznice našla se i misteriozna 'bolest X'. Radilo se o bolesti koju izaziva patogen dosad nepoznat ljudima, koji će se pojaviti zbog kontakta sa životinjama i to negdje gdje su im ljudi oduzeli stanište. Bolest će biti smrtonosnija od gripe i lako će se širiti među ljudima.
Panel je predvidio i da će se, zahvaljujući putovanjima ljudi i trgovinskim mrežama, virus u samo nekoliko tjedana proširiti izvan matičnog kontinenta i da će izazvati veliku globalnu pandemiju te prouzročiti ekonomsku i socijalnu pustoš. Mada je panel time prije svega želio upozoriti na nepripremljenost današnjeg društva na vrlo realan rizik od pojave nepoznate bolesti s teškim posljedicama, nepune dvije godine kasnije njihova se zloslutna prognoza gotovo u slovo obistinjava.
WHO nije jedina organizacija koja se bavi procjenom rizika od pojave novih patogena, a među onima koji su proteklih godina radili na raznim projektima vezanim uz prijetnje javnom zdravlju nalaze se brojni stručnjaci i ustanove. Ono što im je zajedničko to je da smatraju da se adekvatnom pripremom i ova nova pandemija mogla sasjeći u korijenu, no umjesto toga svijet je reagirao na jednak način kao kad se 2002. godine pojavio SARS ili nekoliko godina kasnije, kad je priprijetila tzv. ptičja gripa. Ta reakcija svodi se na paniku, niz mjera koje imaju visoke troškove i kojima se pokušava obuzdati širenje bolesti sve dok znanstvenici ne uspiju pronaći cjepivo ili lijek.
Znanstvenici stoga preporučuju nekoliko programa kojima bi se čovječanstvo moglo bolje pripremiti za iduću pandemiju jer drže da nema sumnje da će do prelaska patogena sa životinja na ljude ponovo doći i da je ključno razviti resurse kojima će se moći vrlo brzo reagirati. Preporuke se svode na troslojnu obranu. Prvi sloj predstavlja pokušaj da se pronađe i identificira stotine tisuća dosad nepoznatih uzročnika koji bi mogli zaprijetiti ljudskom zdravlju. Drugi sloj je stalan nadzor nad uzorcima krvi i drugim indikatorima u regijama u kojima je najviša vjerojatnost pojave novih bolesti. Treći sloj je zajednički program koji bi trebao okupiti sve dosad prikupljene podatke kako bi se stvorila svojevrsna baza za brz razvoj cjepiva i lijekova za nove bolesti.
Iako se čine ambicioznima, planirani koraci i nisu tako neostvarivi. Proteklog desetljeća stručnjaci su pokrenuli nekoliko projekata, od kojih je jedan bio pod imenom Predict. Projektom koji je financirao USAID, američki program za pomoć državama u razvoju, u suradnji s lokalnim timovima u trideset zemalja znanstvenici su uspjeli prikupiti 170 tisuća raznih uzoraka od ljudi i divljih životinja te u tom procesu identificirati 1200 novih virusa koji pripadaju obiteljima virusa poznatim po potencijalu da se šire među ljudima i prouzroče pandemije. Temeljem rezultata tog projekta procijenilo se da postoji između 350 tisuća i 1,3 milijuna nepoznatih virusa koji imaju potencijal širenja na ljude.
Iz te procjene nastao je i projekt Global Virome, čiji bi zadatak bio u idućih desetak godina prikupiti uzorke iz cijelog svijeta kako bi se detektirali milijuni nepoznatih virusa i odredili njihovi genomi. Zahvaljujući napretku tehnologije proces određivanja genoma virusa u proteklih desetak godina bitno je pojeftinio i procjenjuje se da bi trošak predloženog projekta bio na razini od četiri milijarde dolara. U usporedbi sa stotinama milijardi koje se diljem svijeta svake godine troše na naoružanje, cijena projekta od kojeg bi korist imalo cijelo čovječanstvo gotovo je zanemariva. Dodatni, jeftiniji, prijedlog za tek četvrtinu spomenutog iznosa obuhvatio bi one države u kojima je rizik najviši, a znanstvenici koji su predložili projekt smatraju da bi se time moglo prikupiti i 70 posto potrebnih podataka.
Na ovaj način stvorila bi se baza podataka o genomima virusa koja bi se usporedbom poznatih genoma s onima tek otkrivenima mogla koristiti za predviđanje gdje postoji najveća vjerojatnost da bi moglo doći do pojave novih bolesti, odnosno kojim virusima je potrebno najmanje mutacija da bi se pojavili među ljudima. Projekt bi pomogao brzoj identifikaciji virusa u regijama u kojima dolazi do jačeg miješanja između ljudi i životinja.
Drugi, sličan projekt pod nazivom Vizions provodio se u Vijetnamu od 2011. do 2017. i uključivao je uzimanje brojnih krvnih i fekalnih uzoraka od ljudi i životinja, posebno tamo gdje postoji veliko međusobno miješanje, bilo to u pogonima za uzgoj životinja ili u ruralnim područjima u kojima do miješanja dolazi prirodno. Cilj projekta bila je izrada lokalnih kapaciteta za katalogiziranje raznolikosti virusa među životinjama, od kojih bi neki mogli postati prijetnja ljudima.
Temeljem tog lokaliziranog projekta pojavila se ideja o globalnoj mreži koja bi motrila krvne uzorke iz cijelog svijeta, inače uzete za kliničke svrhe, s ciljem identifikacije pojave novih virusa. Takva bi mreža pomogla ne samo u identificiranju lokaliteta novih potencijalnih pandemija, već bi omogućila praćenje imunološkog odgovora koji razvija ljudski organizam. Potencijalni problem s takvim prikupljanjem jest dijeljenje privatnih informacija oboljelih, kao i nevoljkost vlada da predaju takve informacije zbog straha da bi ih to stajalo ugleda u svijetu pojavi li se neka nova bolest baš kod njih. Primjer Kine, za koju se sumnja da je odugovlačila s objavom informacija o novom koronavirusu, najbolja je ilustracija za to.
Dodatna korist stvaranja takvih baza podataka bila bi mogućnost znanstvenika i istraživača da dobiju okvirne informacije o mogućim cjepivima i tretmanima za nove viruse i bolesti. Podaci o genomima virusa omogućili bi testiranja za postojeće lijekove i cjepiva i tako bi se mogla stvoriti određena prednost i potencijal za bržu reakciju kad stvarno dođe do širenja neke dotad nepoznate bolesti među ljudima.
Spomenuti ciljevi i planovi koji bi čovječanstvu mogli olakšati borbu s rizicima od raznih novih bolesti nisu neka prevelika novost. No dosad se o njima raspravljalo tek na stručnim panelima daleko od pažnje javnosti. Aktualna pandemija, koliko god da je problema prouzročila, mogla bi poslužiti i za rast svijesti o takvim inicijativama, a iz toga bi se mogle izroditi i konkretne akcije. Nije da su nam potrebni dodatni dokazi o njihovoj nužnosti.